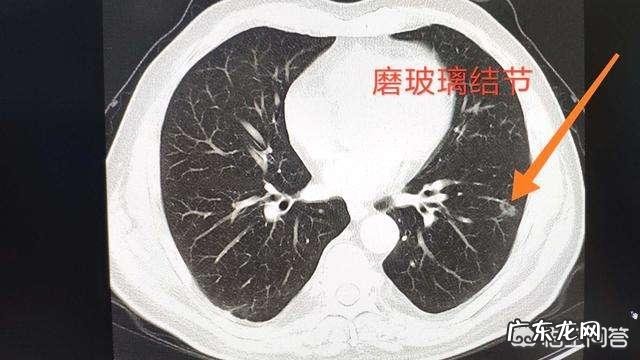
活动量大了后背肌肉疼,肋骨疼是怎么回事?跪求解答谢谢?

凡由于外伤,引起胸胁部气机壅滞,出现胸部板紧掣痛,胸闷不舒的症状,称为胸部屏岔气伤,即为,胸胁屏伤 。多因急性外伤,如提拉举重,活动量过度,姿势不良,用力不当,旋转扭错而导致胸壁固有肌肉的撕裂,痉挛或推肋关节脱位,滑膜嵌顿等,使胸胁迫气机壅滞不畅,久之胸部呈板紧掣痛 。主证,典型扭伤史,伤后即出现一侧胸胁部疼痛,咳嗽或呼吸时疼痛加重,并牵扯背部疼痛部位逐渐扩大,由于范围较广泛而无定处,患者保护性地减小呼吸幅度,形成浅促的呼吸,伴有胸闷不适 。分析,当身体受到过猛的扭错性外力时,则可引起关节半脱位,从而压迫肋间神经,引起疼痛,同时在身体扭转时可造成某一方位的关节间隙张开,而后松弛的关节滑膜嵌入其间,关节间滑膜有丰富的感觉神经末稍,故嵌入后即可引起疼痛,同时出现急性损伤性病理反应,故而发生保护性减小呼吸幅度,形成浅促的呼吸,伴有胸闷不适等肋间神经刺激征 。均属胸胁部气机壅滞,经络闭阻之象 。注意,无论举重、或提物均有一定准备,不可疏忽大意 。劳动,操作中要思想集中,避免气机阻滞的发生 。
恶性的肺结节有哪些特征?近年来,随着检查仪器的精度提高和大众健康体检意识的普及,越来越多的肺部结节被发现 。作为临床一线的呼吸科医生,最直观的感受是,前些年在门诊差不多一周才能见到几个肺结节,到如今已经占门诊就诊患者的很大比例 。有人体检发现肺部有结节后,情绪异常紧张,寝食不安,不加区别地要求医生为其切除 。有一部分患者,虽然在听了医生的专业讲解之后,心情得到了暂缓的放松,但几天之后再次陷入深度焦虑之中,随访中途,隔一个月就去看门诊 。焦虑与恐惧,持续反复 。这其中的原因就是他们会无形中把肺结节与肺癌划上等号 。

文章插图

文章插图
实际上,在检出的肺部小结节中,绝大多数是良性结节,3mm以下的结节癌变可能性仅0.2%,直径≤6mm实性小结节绝大部分良性,恶性概率小于1% 。那么,恶性肺结节有哪些特征呢?
【活动量大了后背肌肉疼,肋骨疼是怎么回事?跪求解答谢谢?】
文章插图
1.结节大小 结节越大恶性可能性越大,结节直径大于8 mm时,孤立性肺结节为恶性病变的概率明显增高 。直径在1.5cm以上的实性结节及8mm以上的磨玻璃结节需要注意 。

文章插图

文章插图
2.结节位置 约60%的孤立性肺结节位于肺的周围区域,多数恶性结节位于肺上叶,尤其是两肺上叶前段 。上叶尖后段、下叶背段则多为良性病变,尤其是结核灶 。
3.结节形态 CT上结节如果有下列征象需要警惕恶性可能,如:结节边缘不光滑、密度不均匀、形态不规则、有分叶、有毛刺、有胸膜牵拉、结节内小气道管壁局限性增厚、出现含气细支气管征和小泡征、偏心厚壁空洞等 。恶性结节空洞通常壁厚薄不均,内壁不规则、出现壁结节是诊断恶性结节的可靠征象 。此外,1cm内的实性小结节恶性概率低,而纯磨玻璃结节和部分实性磨玻璃结节恶性概率略高,需要加强随访 。
4.结节生长速度 恶性结节通常是缓慢生长,细胞倍增时间在3-18个月 。如果结节在1个月内明显增大,恶性可能性比较小,炎症、梗死可能性大 。病灶尺寸 2 年以上稳定不变,结节通常是良性病变 。但怀疑腺癌的非实性结节随访时间要延长,因其通常为贴壁生长,生长速度很慢 。
- 淘口令怎么打开?复制了淘口令没有弹窗怎么回事?
- 淘宝橱窗推荐在哪里?淘宝橱窗推荐怎么没了?
- 淘宝开票信息是开了会有记录吗?怎么维护?
- 2022年淘宝母亲节有活动吗?活动力度大吗?
- 淘宝母亲节活动怎么参加?参加活动有什么优势
- 淘宝母亲节活动时间是哪天?活动规则是什么?
- 您的体重指数是多少超过这个数就该减肥了
- 双二十在即,各大电商促销活动来袭
- 家里有阳台,不能少了“这五样”,真不是迷信,是老一辈的经验
- 京东、淘宝开启双12预热活动
特别声明:本站内容均来自网友提供或互联网,仅供参考,请勿用于商业和其他非法用途。如果侵犯了您的权益请与我们联系,我们将在24小时内删除。
